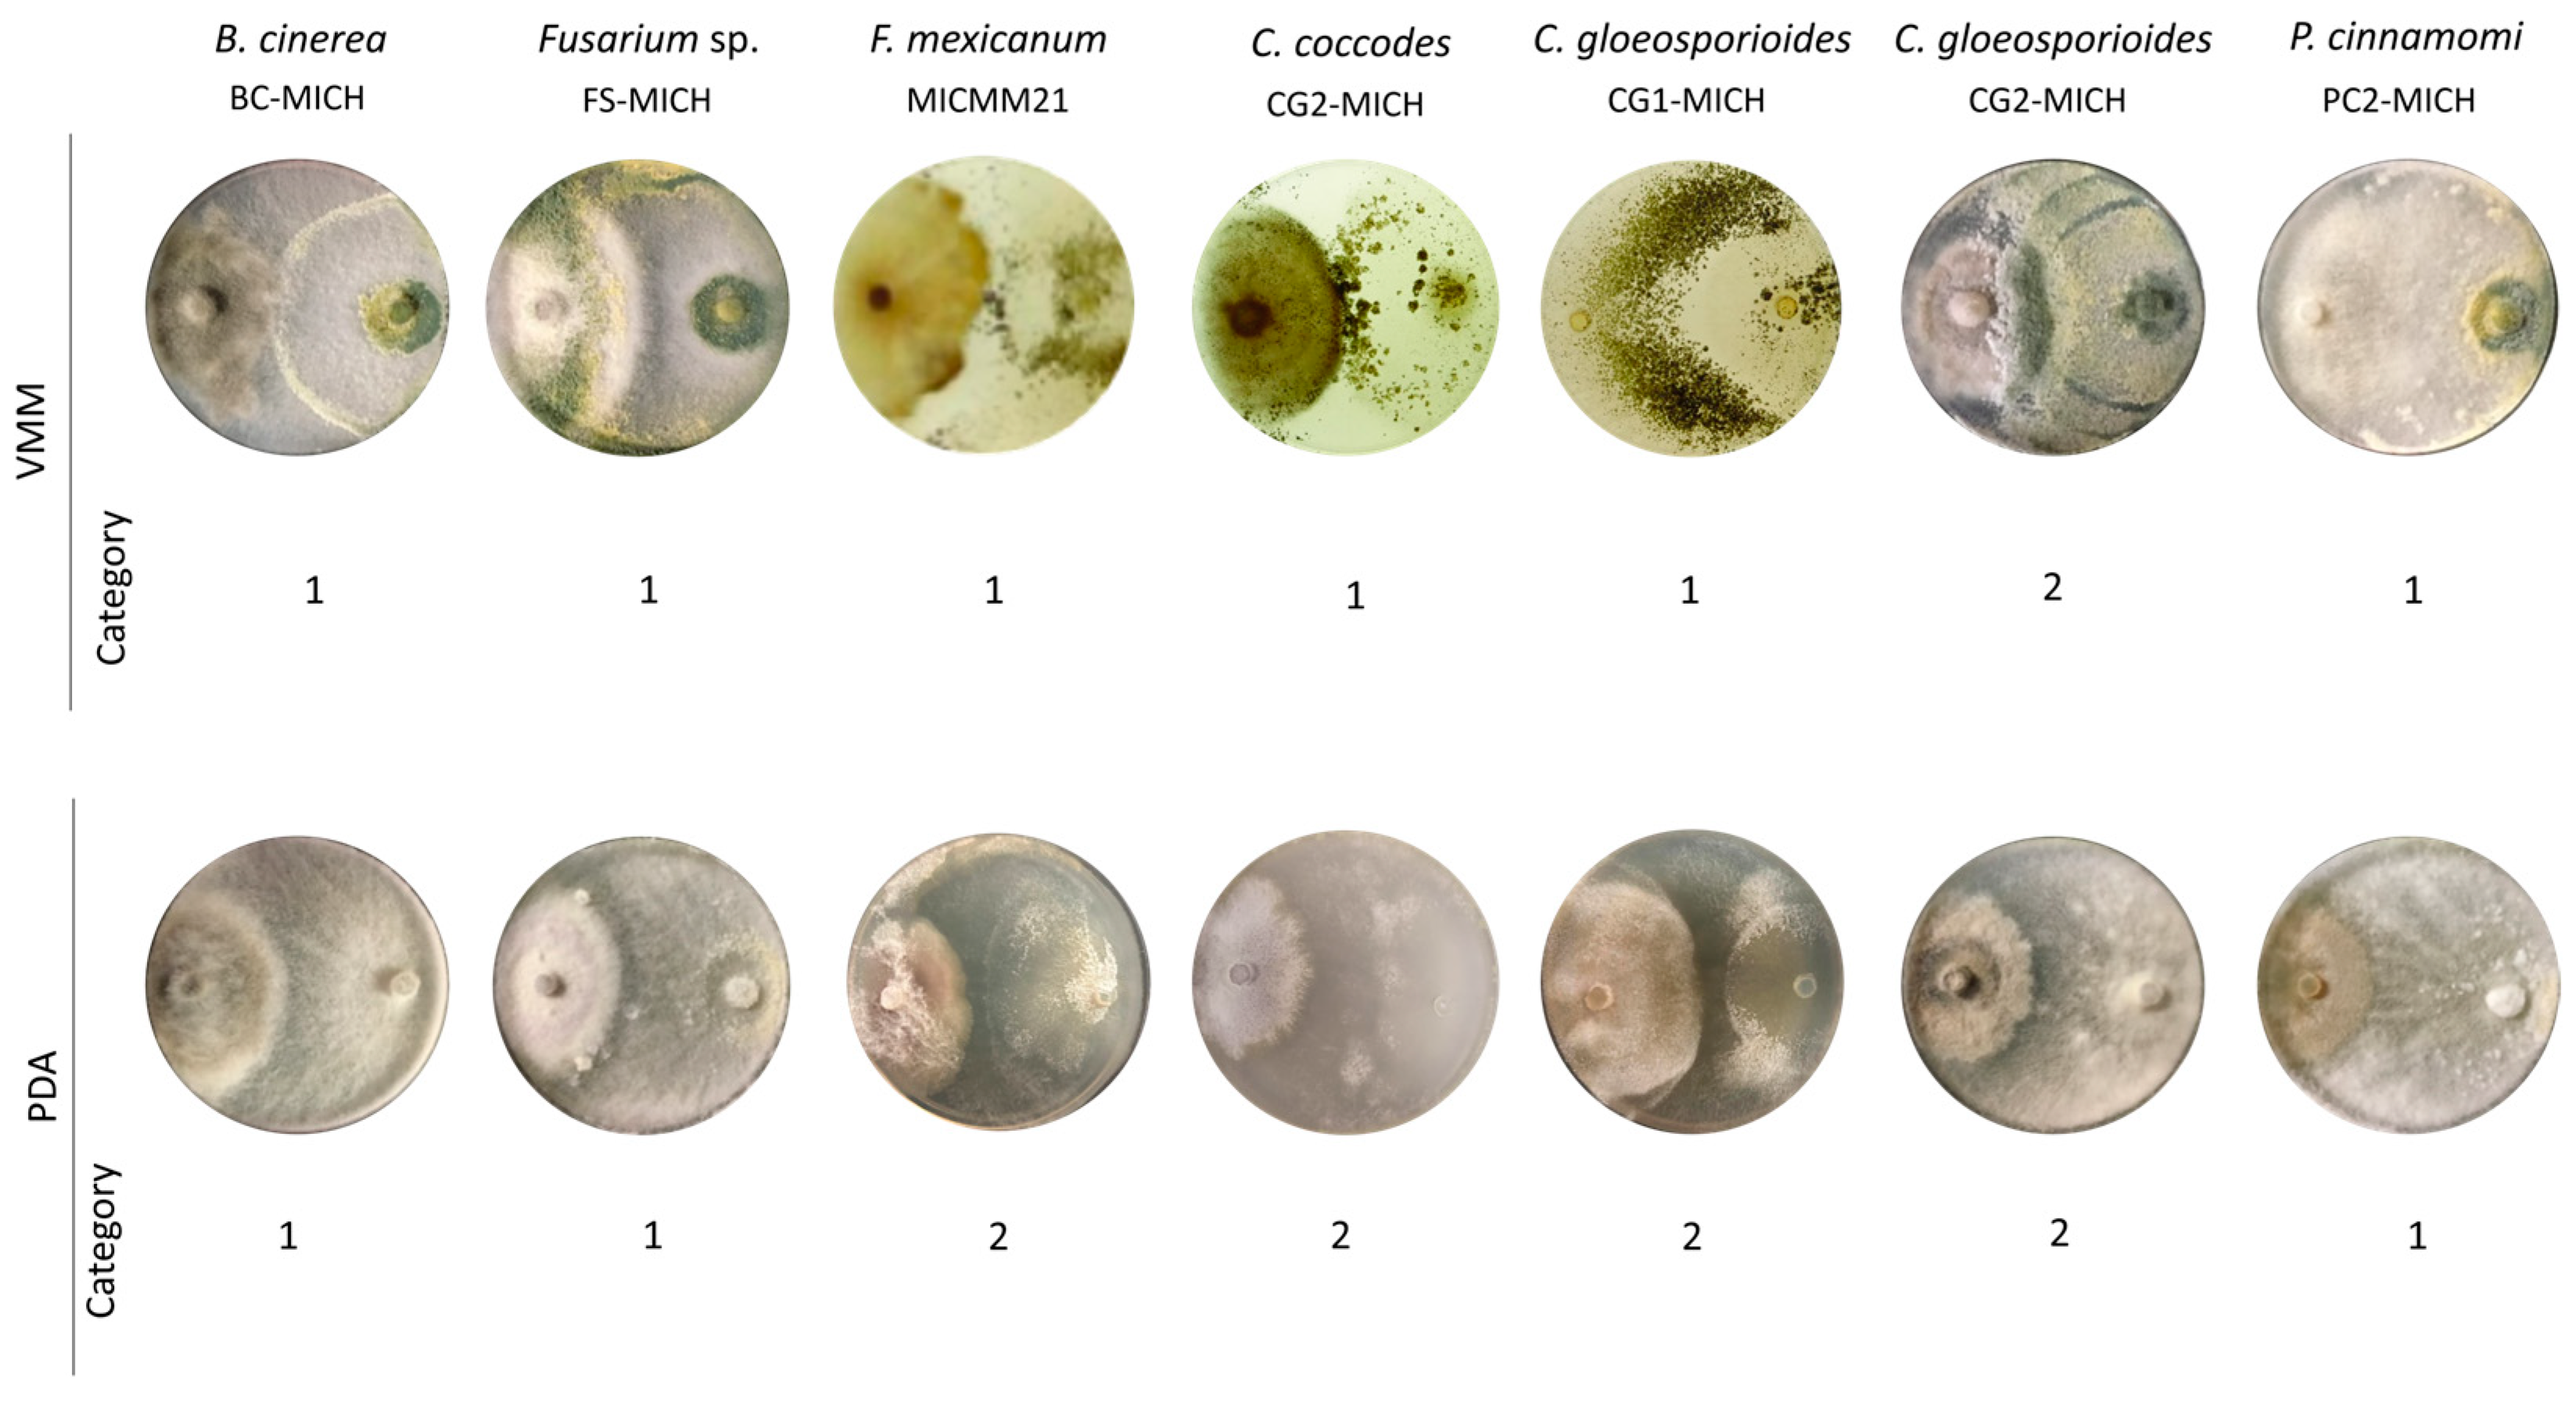
Jof 10 00758 g003 Jof 10 00758 g003

Polyphasic Characterization of the Biocontrol Potential of a Novel Strain of Trichoderma atroviride Isolated from Central Mexico
Abstract
1. Introduction
2. Materials and Methods
2.1. Analyzed Strains
2.2. Inoculum Generation
2.3. Growth Kinetics
2.3.1. Growth Kinetics in Solid Medium
2.3.2. Growth Kinetics in Liquid Medium
2.4. Confrontation Assays in Dual Culture
2.5. Assays of the Growth Inhibition of Phytopathogens
2.5.1. Inhibition by Non-Volatile Metabolites
2.5.2. Inhibition by Volatile Metabolites (VOCs)
2.6. Scanning Electron Microscopy of Confrontation Assays
2.7. In Vitro Inhibition Assays of Botrytis cinerea with the Extracellular Filtrate of the Liquid Culture of T. atroviride
2.8. Inhibition of Phytopathogens Using Concentrates of the Extracellular Filtrate from T. atroviride Liquid Culture
2.9. Inhibition of Phytopathogens with Lyophilized Extracellular Filtrate from Liquid Culture of T. atroviride
2.10. Botrytis Cinerea Growth Inhibition Tests on Leaf Tissue
2.10.1. Inhibition Assays by Soluble Metabolites
2.10.2. Inhibition Assays by VOCs
2.11. Quantitative Determination of the Enzymatic Activity of Chitinase
2.12. Chitinase Gene Expression Assays
2.13. Phylogenetic and Structural Analyses of the Chitinase Encoded in the TRIATDRAFT_217415 Locus of T. atroviride
2.14. Statistical Analysis
3. Results
3.1. Growth Kinetics
3.2. Antagonism Assays
Antagonism Assays in Dual Culture
3.3. In Vitro Inhibition Assays
3.3.1. Inhibition by Non-Volatile Metabolites
3.3.2. Inhibition by Volatile Metabolites (VOCs)
3.4. Mycoparasitism-Related Structures
3.5. In Vitro Inhibition Assays of B. cinerea by Extracellular Filtrates of T. atroviride Strain CMU-08
3.6. Reduction in Leaf Damage in Tomato Leaf Assays
3.7. Quantitative Determination of Chitinase Activity
3.8. Expression of Chitinase Genes in CMU-08 Strain
3.9. Phylogenetic and Structural Analyses of the Chitinase Encoded in the TRIATDRAFT_217415 Locus
4. Discussion
5. Conclusions
Supplementary Materials
Author Contributions
Funding
Institutional Review Board Statement
Informed Consent Statement
Data Availability Statement
Acknowledgments
Conflicts of Interest
References
- FAO. The State of Food and Agriculture 2021. Making Agrifood Systems More Resilient to Shocks and Stresses; FAO: Rome, Italy, 2021. [Google Scholar] [CrossRef]
- FAO; IFAD; UNICEF; WFP; WHO. The State of Food Security and Nutrition in the World 2022. Repurposing Food and Agricultural Policies to Make Healthy Diets More Affordable; FAO: Rome, Italy, 2022. [Google Scholar] [CrossRef]
- Hunter, M.C.; Smith, R.G.; Schipanski, M.E.; Atwood, L.W.; Mortensen, D.A. Agriculture in 2050: Recalibrating targets for sustainable intensification. BioScience 2017, 67, 386–391. [Google Scholar] [CrossRef]
- Mwalupaso, G.E.; Korotoumou, M.; Eshetie, A.M.; Alavo, J.P.E.; Tian, X. Recuperating dynamism in agriculture through adoption of sustainable agricultural technology-Implications for cleaner production. J. Cleaner Prod. 2019, 232, 639–647. [Google Scholar] [CrossRef]
- He, D.C.; Zhan, J.S.; Xie, L.H. Problems, challenges and future of plant disease management: From an ecological point of view. J. Integr. Agric. 2016, 15, 705–715. [Google Scholar] [CrossRef]
- Fones, H.N.; Bebber, D.P.; Chaloner, T.M.; Kay, W.T.; Steinberg, G.; Gurr, S.J. Threats to global food security from emerging fungal and oomycete crop pathogens. Nat. Food 2020, 1, 332–342. [Google Scholar] [CrossRef]
- Sood, M.; Kapoor, D.; Kumar, V.; Sheteiwy, M.S.; Ramakrishnan, M.; Landi, M.; Araniti, F.; Sharma, A. Trichoderma: The “secrets” of a multitalented biocontrol agent. Plants 2020, 9, 762. [Google Scholar] [CrossRef]
- Lucas, J.A.; Hawkins, N.J.; Fraaije, B.A. The evolution of fungicide resistance. Adv. Appl. Microbiol. 2015, 90, 29–92. [Google Scholar] [CrossRef]
- Hu, Z. What socio-economic and political factors lead to global pesticide dependence? A critical review from a social science perspective. Int. J. Environ. Res. Public Health 2020, 17, 8119. [Google Scholar] [CrossRef]
- Rani, L.; Thapa, K.; Kanojia, N.; Sharma, N.; Singh, S.; Grewal, A.S.; Srivastav, A.L.; Kaushal, J. An extensive review on the consequences of chemical pesticides on human health and environment. J. Clean. Prod. 2021, 283, 124657. [Google Scholar] [CrossRef]
- Estep, L.K.; Torriani, S.F.; Zala, M.; Anderson, N.P.; Flowers, M.D.; McDonald, B.A.; Mundt, C.C.; Brunner, P.C. Emergence and early evolution of fungicide resistance in North American populations of Zymoseptoria tritici. Plant Pathol. 2015, 64, 961–971. [Google Scholar] [CrossRef]
- Brauer, V.S.; Rezende, C.P.; Pessoni, A.M.; De Paula, R.G.; Rangappa, K.S.; Nayaka, S.C.; Gupta, V.K.; Almeida, F. Antifungal agents in agriculture: Friends and foes of public health. Biomolecules 2019, 9, 521. [Google Scholar] [CrossRef]
- Sánchez-Torres, P. Molecular mechanisms underlying fungicide resistance in citrus postharvest green mold. J. Fungi 2021, 7, 783. [Google Scholar] [CrossRef]
- Zhang, X.; Huang, K.; Zhang, M.; Jiang, L.; Wang, Y.; Feng, J.; Ma, Z. Biochemical and genetic characterization of Botrytis cinerea laboratory mutants resistant to propamidine. Pest Manag. Sci. 2022, 78, 5281–5292. [Google Scholar] [CrossRef]
- Ab Rahman, S.F.S.; Singh, E.; Pieterse, C.M.; Schenk, P.M. Emerging microbial biocontrol strategies for plant pathogens. Plant Sci. 2018, 267, 102–111. [Google Scholar] [CrossRef]
- Pirttilä, A.M.; Habibollah-Mohammad, P.T.; Baruah, N.; Koskimäki, J.J. Biofertilizers and biocontrol agents for agriculture: How to identify and develop new potent microbial strains and traits. Microorganisms 2021, 9, 817. [Google Scholar] [CrossRef]
- Lahlali, R.; Ezrari, S.; Radouane, N.; Kenfaoui, J.; Esmaeel, Q.; El Hamss, H.; Belabess, Z.; Barka, E.A. Biological control of plant pathogens: A global perspective. Microorganisms 2022, 10, 596. [Google Scholar] [CrossRef]
- Zin, N.A.; Badaluddin, N.A. Biological functions of Trichoderma spp. for agriculture applications. Ann. Agric. Sci. 2020, 65, 168–178. [Google Scholar] [CrossRef]
- Tyśkiewicz, R.; Nowak, A.; Ozimek, E.; Jaroszuk-Ściseł, J. Trichoderma: The current status of its application in agriculture for the biocontrol of fungal phytopathogens and stimulation of plant growth. Int. J. Mol. Sci. 2022, 23, 2329. [Google Scholar] [CrossRef]
- Modrzewska, M.; Bryła, M.; Kanabus, J.; Pierzgalski, A. Trichoderma as a biostimulator and biocontrol agent against Fusarium in the production of cereal crops: Opportunities and possibilities. Plant Pathol. 2022, 71, 1471–1485. [Google Scholar] [CrossRef]
- Ristaino, J.B.; Anderson, P.K.; Bebber, D.P.; Brauman, K.A.; Cunniffe, N.J.; Fedoroff, N.V.; Garrett, K.A.; Gilligan, C.A.; Jones, C.M.; Martin, M.D.; et al. The persistent threat of emerging plant disease pandemics to global food security. Proc. Natl. Acad. Sci. USA 2021, 118, e2022239118. [Google Scholar] [CrossRef]
- Corredor-Moreno, P.; Saunders, D.G. Expecting the unexpected: Factors influencing the emergence of fungal and oomycete plant pathogens. New Phytol. 2020, 225, 118–125. [Google Scholar] [CrossRef]
- Truong, N.V.; Burgess, L.W.; Liew, E.C. Cross-infectivity and genetic variation of Phytophthora capsici isolates from chilli and black pepper in Vietnam. Australas. Plant Pathol. 2012, 41, 439–447. [Google Scholar] [CrossRef]
- Papaioannou, I.A.; Ligoxigakis, E.K.; Vakalounakis, D.J.; Markakis, E.A.; Typas, M.A. Phytopathogenic, morphological, genetic and molecular characterization of a Verticillium dahliae population from Crete, Greece. Eur. J. Plant Pathol. 2013, 136, 577–596. [Google Scholar] [CrossRef]
- da Silva, L.L.; Moreno, H.L.A.; Correia, H.L.N.; Santana, M.F.; de Queiroz, M.V. Colletotrichum: Species complexes, lifestyle, and peculiarities of some sources of genetic variability. Appl. Microbiol. Biotechnol. 2020, 104, 1891–1904. [Google Scholar] [CrossRef]
- Gorshkov, V.; Osipova, E.; Ponomareva, M.; Ponomarev, S.; Gogoleva, N.; Petrova, O.; Gogoleva, O.; Meshcherov, A.; Balkin, A.; Vetchinkina, E.; et al. Rye snow mold-associated Microdochium nivale strains inhabiting a common area: Variability in genetics, morphotype, extracellular enzymatic activities, and virulence. J. Fungi 2020, 6, 335. [Google Scholar] [CrossRef]
- Ma, Z.; Liu, B.; He, S.; Gao, Z. Analysis of physiological races and genetic diversity of Setosphaeria turcica (Luttr.) KJ Leonard & Suggs from different regions of China. Can. J. Plant Pathol. 2020, 42, 396–407. [Google Scholar] [CrossRef]
- Saleh, A.A.; Sharafaddin, A.H.; El_Komy, M.H.; Ibrahim, Y.E.; Hamad, Y.K. Molecular and physiological characterization of Fusarium strains associated with different diseases in date palm. PLoS ONE 2021, 16, e0254170. [Google Scholar] [CrossRef]
- Viejobueno, J.; de Los Santos, B.; Camacho-Sanchez, M.; Aguado, A.; Camacho, M.; Salazar, S.M. Phenotypic variability and genetic diversity of the pathogenic fungus Macrophomina phaseolina from several hosts and host specialization in strawberry. Curr. Microbiol. 2022, 79, 189. [Google Scholar] [CrossRef]
- Elad, Y.; Pertot, I. Climate change impacts on plant pathogens and plant diseases. J. Crop Improv. 2014, 28, 99–139. [Google Scholar] [CrossRef]
- Almeida, F.; Rodrigues, M.L.; Coelho, C. The still underestimated problem of fungal diseases worldwide. Front. Microbiol. 2019, 10, 214. [Google Scholar] [CrossRef]
- Wu, E.J.; Wang, Y.P.; Yahuza, L.; He, M.H.; Sun, D.L.; Huang, Y.M.; Liu, Y.C.; Yang, L.N.; Zhu, W.; Zhan, J. Rapid adaptation of the Irish potato famine pathogen Phytophthora infestans to changing temperature. Evol. Appl. 2020, 13, 768–780. [Google Scholar] [CrossRef]
- Desaint, H.; Aoun, N.; Deslandes, L.; Vailleau, F.; Roux, F.; Berthomé, R. Fight hard or die trying: When plants face pathogens under heat stress. New Phytol. 2021, 229, 712–734. [Google Scholar] [CrossRef]
- Alfiky, A.; Weisskopf, L. Deciphering Trichoderma–plant–pathogen interactions for better development of biocontrol applications. J. Fungi 2021, 7, 61. [Google Scholar] [CrossRef]
- Guzmán-Guzmán, P.; Porras-Troncoso, M.D.; Olmedo-Monfil, V.; Herrera-Estrella, A. Trichoderma species: Versatile plant symbionts. Phytopathology 2019, 109, 6–16. [Google Scholar] [CrossRef]
- Rocha-Ramírez, V.; Omero, C.; Chet, I.; Horwitz, B.A.; Herrera-Estrella, A. Trichoderma atroviride G-protein α-subunit gene tga1 is involved in mycoparasitic coiling and conidiation. Eukaryot. Cell 2002, 1, 594–605. [Google Scholar] [CrossRef]
- Zembek, P.; Perlińska-Lenart, U.; Brunner, K.; Reithner, B.; Palamarczyk, G.; Mach, R.L.; Kruszewska, J.S. Elevated activity of dolichyl phosphate mannose synthase enhances biocontrol abilities of Trichoderma atroviride. Mol. Plant-Microbe Interact. 2011, 24, 1522–1529. [Google Scholar] [CrossRef]
- Aghcheh, R.K.; Druzhinina, I.S.; Kubicek, C.P. The putative protein methyltransferase LAE1 of Trichoderma atroviride is a key regulator of asexual development and mycoparasitism. PLoS ONE 2013, 8, e67144. [Google Scholar] [CrossRef]
- Salas-Marina, M.A.; Isordia-Jasso, M.I.; Islas-Osuna, M.A.; Delgado-Sánchez, P.; Jiménez-Bremont, J.F.; Rodríguez-Kessler, M.; Rosales-Saavedra, M.T.; Herrera-Estrella, A.; Casas-Flores, S. The Epl1 and Sm1 proteins from Trichoderma atroviride and Trichoderma virens differentially modulate systemic disease resistance against different life style pathogens in Solanum lycopersicum. Front. Plant Sci. 2015, 6, 77. [Google Scholar] [CrossRef]
- Garnica-Vergara, A.; Barrera-Ortiz, S.; Muñoz-Parra, E.; Raya-González, J.; Méndez-Bravo, A.; Macías-Rodríguez, L.; Ruiz-Herrera, L.F.; López-Bucio, J. The volatile 6-pentyl-2H-pyran-2-one from Trichoderma atroviride regulates Arabidopsis thaliana root morphogenesis via auxin signaling and ETHYLENE INSENSITIVE 2 functioning. New Phytol. 2016, 209, 1496–1512. [Google Scholar] [CrossRef]
- Coppola, M.; Cascone, P.; Lelio, I.D.; Woo, S.L.; Lorito, M.; Rao, R.; Pennacchio, F.; Guerrieri, E.; Digilio, M.C. Trichoderma atroviride P1 colonization of tomato plants enhances both direct and indirect defense barriers against insects. Front. Physiol. 2019, 10, 813. [Google Scholar] [CrossRef]
- Cruz-Magalhães, V.; Nieto-Jacobo, M.F.; van Zijll de Jong, E.; Rostás, M.; Padilla-Arizmendi, F.; Kandula, D.; Kandula, J.; Hampton, J.; Herrera-Estrella, A.; Steyaert, J.M.; et al. The NADPH oxidases Nox1 and Nox2 differentially regulate volatile organic compounds, fungistatic activity, plant growth promotion and nutrient assimilation in Trichoderma atroviride. Front. Microbiol. 2019, 9, 3271. [Google Scholar] [CrossRef]
- Speckbacher, V.; Ruzsanyi, V.; Wigger, M.; Zeilinger, S. The Trichoderma atroviride strains P1 and IMI 206040 differ in their light-response and VOC production. Molecules 2020, 25, 208. [Google Scholar] [CrossRef]
- Moreno-Ruiz, D.; Salzmann, L.; Fricker, M.D.; Zeilinger, S.; Lichius, A. Stress-activated protein kinase signalling regulates mycoparasitic hyphal-hyphal interactions in Trichoderma atroviride. J. Fungi 2021, 7, 365. [Google Scholar] [CrossRef]
- Schubert, M.; Mourad, S.; Fink, S.; Schwarze, F.W.M.R. Ecophysiological responses of the biocontrol agent Trichoderma atroviride (T-15603.1) to combined environmental parameters. Biol. Control 2009, 49, 84–90. [Google Scholar] [CrossRef]
- Jeleń, H.; Błaszczyk, L.; Chełkowski, J.; Rogowicz, K.; Strakowska, J. Formation of 6-n-pentyl-2H-pyran-2-one (6-PAP) and other volatiles by different Trichoderma species. Mycol. Prog. 2014, 13, 589–600. [Google Scholar] [CrossRef]
- Daryaei, A.; Jones, E.E.; Glare, T.R.; Falloon, R.E. pH and water activity in culture media affect biological control activity of Trichoderma atroviride against Rhizoctonia solani. Biol. Control 2016, 92, 24–30. [Google Scholar] [CrossRef]
- Lange, C.; Weld, R.J.; Cox, M.P.; Bradshaw, R.E.; McLean, K.L.; Stewart, A.; Steyaert, J.M. Genome-scale investigation of phenotypically distinct but nearly clonal Trichoderma strains. PeerJ. 2016, 4, e2023. [Google Scholar] [CrossRef]
- Grzegorczyk, M.; Kancelista, A.; Łaba, W.; Piegza, M.; Witkowska, D. The effect of lyophilization and storage time on the survival rate and hydrolytic activity of Trichoderma strains. Folia Microbiol. 2018, 63, 433–441. [Google Scholar] [CrossRef]
- Stracquadanio, C.; Quiles, J.M.; Meca, G.; Cacciola, S.O. Antifungal activity of bioactive metabolites produced by Trichoderma asperellum and Trichoderma atroviride in liquid medium. J. Fungi 2020, 6, 263. [Google Scholar] [CrossRef]
- You, J.; Zhang, J.; Wu, M.; Yang, L.; Chen, W.; Li, G. Multiple criteria-based screening of Trichoderma isolates for biological control of Botrytis cinerea on tomato. Biol. Control 2016, 101, 31–38. [Google Scholar] [CrossRef]
- Raymaekers, K.; Ponet, L.; Holtappels, D.; Berckmans, B.; Cammue, B.P. Screening for novel biocontrol agents applicable in plant disease management—A review. Biol. Control 2020, 144, 104240. [Google Scholar] [CrossRef]
- Larralde-Corona, C.P.; Santiago-Mena, M.R.; Sifuentes-Rincon, A.M.; Rodríguez-Luna, I.C.; Rodriguez-Perez, M.A.; Shirai, K.; Narvaez-Zapata, J.A. Biocontrol potential and polyphasic characterization of novel native Trichoderma strains against Macrophomina phaseolina isolated from sorghum and common bean. Appl. Microbiol. Biotechnol. 2008, 80, 167–177. [Google Scholar] [CrossRef]
- John, N.S.; Anjanadevi, I.P.; Nath, V.S.; Sankar, S.A.; Jeeva, M.L.; John, K.S.; Misra, R.S. Characterization of Trichoderma isolates against Sclerotium rolfsii, the collar rot pathogen of Amorphophallus–a polyphasic approach. Biol. Control 2015, 90, 164–172. [Google Scholar] [CrossRef]
- Cázares-García, S.V.; Arredondo-Santoyo, M.; Vázquez-Marrufo, G.; Vázquez-Garcidueñas, M.S.; Robinson-Fuentes, V.A.; Gómez-Reyes, V.M. Typing and selection of wild strains of Trichoderma spp. producers of extracellular laccase. Biotechnol. Prog. 2016, 32, 787–798. [Google Scholar] [CrossRef]
- Cherif, S.S.; Benhamou, C.S. Cytochemical aspects of chitin breakdown during the parasitic action of a Trichoderma spp., on Fusarium oxysporum f. sp. radicislycopersici. Phytopathology 1990, 80, 1406–1414. [Google Scholar] [CrossRef]
- Bell, D.K.; Wells, H.D.; Markham, C.R. In vitro antagonism of Trichoderma species against six fungal plant pathogens. Phytopathology 1982, 72, 379–382. [Google Scholar] [CrossRef]
- Dennis, C.; Webster, J. Antagonistic properties of species-groups of Trichoderma. I. Production of nonvolatile antibiotics. Trans. Br. Mycol. Soc. 1971, 57, 25–39. [Google Scholar] [CrossRef]
- Worasatit, N.; Sivasithamparam, K.; Ghisalberti, E.L.; Rowland, C. Variation in pyrone production, lytic enzymes and control of Rhizoctonia root rot of wheat among single-spore isolates of Trichoderma koningii. Mycol. Res. 1994, 98, 1357–1363. [Google Scholar] [CrossRef]
- Nutter, F.W.; Esker, P.D.; Netto, R.A.C. Disease assessment concepts and the advancements made in improving the accuracy and precision of plant disease data. Eur. J. Plant Pathol. 2006, 115, 95–103. [Google Scholar] [CrossRef]
- Sarven, M.S.; Hao, Q.; Deng, J.; Yang, F.; Wang, G.; Xiao, Y.; Xiao, X. Biological control of tomato gray mold caused by Botrytis cinerea with the entomopathogenic fungus Metarhizium anisopliae. Pathogens 2020, 9, 213. [Google Scholar] [CrossRef]
- Qualhato, T.F.; Lopes, F.A.C.; Steindorff, A.S.; Brandao, R.S.; Jesuino, R.S.A.; Ulhoa, C.J. Mycoparasitism studies of Trichoderma species against three phytopathogenic fungi: Evaluation of antagonism and hydrolytic enzyme production. Biotechnol. Lett. 2013, 35, 1461–1468. [Google Scholar] [CrossRef]
- Gruber, S.; Vaaje-Kolstad, G.; Matarese, F.; López-Mondéjar, R.; Kubicek, C.P.; Seidl-Seiboth, V. Analysis of subgroup C of fungal chitinases containing chitin-binding and LysM modules in the mycoparasite Trichoderma atroviride. Glycobiology 2011, 21, 122–133. [Google Scholar] [CrossRef]
- Livak, K.J.; Schmittgen, T.D. Analysis of relative gene expression data using real-time quantitative PCR and the 2−ΔΔCT method. Methods 2001, 25, 402–408. [Google Scholar] [CrossRef]
- Seidl-Seiboth, V.; Ihrmark, K.; Druzhinina, I.; Karlsson, M. Molecular evolution of Trichoderma chitinases. In Biotechnology and biology of Trichoderma; Gupta, V.K., Schmoll, M., Herrera-Estrella, A., Upadhyay, R.S., Druzhinina, I., Tuohy, M.G., Eds.; Elsevier: Oxford, UK, 2014; pp. 67–78. [Google Scholar] [CrossRef]
- Goughenour, K.D.; Whalin, J.; Slot, J.C.; Rappleye, C.A. Diversification of fungal chitinases and their functional differentiation in Histoplasma capsulatum. Mol. Biol. Evol. 2021, 38, 1339–1355. [Google Scholar] [CrossRef]
- Wang, C.; Zeng, Z.Q.; Zhuang, W.Y. Comparative molecular evolution of chitinases in ascomycota with emphasis on mycoparasitism lifestyle. Microb. Genom. 2021, 7, 000646. [Google Scholar] [CrossRef]
- Katoh, K.; Rozewicki, J.; Yamada, K.D. MAFFT online service: Multiple sequence alignment, interactive sequence choice and visualization. Brief Bioinform. 2019, 20, 1160–1166. [Google Scholar] [CrossRef]
- Sela, I.; Ashkenazy, H.; Katoh, K.; Pupko, T. GUIDANCE2: Accurate detection of unreliable alignment regions accounting for the uncertainty of multiple parameters. Nucleic Acids Res. 2015, 43, W7–W14. [Google Scholar] [CrossRef]
- Nguyen, L.T.; Schmidt, H.A.; Von Haeseler, A.; Minh, B.Q. IQ-TREE: A fast and effective stochastic algorithm for estimating maximum likelihood phylogenies. Mol. Biol. Evol. 2015, 32, 268–274. [Google Scholar] [CrossRef]
- Trifinopoulos, J.; Nguyen, L.T.; Von Haeseler, A.; Minh, B.Q. W-IQ-TREE: A fast online phylogenetic tool for maximum likelihood analysis. Nucleic Acids Res. 2016, 44, 232–235. [Google Scholar] [CrossRef]
- Hoang, D.T.; Chernomor, O.; Von Haeseler, A.; Minh, B.Q.; Vinh, L.S. UFBoot2: Improving the ultrafast bootstrap approximation. Mol. Biol. Evol. 2018, 35, 518–522. [Google Scholar] [CrossRef]
- Letunic, I.; Bork, P. Interactive Tree of Life (iTOL) v6: Recent updates to the phylogenetic tree display and annotation tool. Nucleic Acids Res. 2024, 52, W78–W82. [Google Scholar] [CrossRef]
- Waterhouse, A.; Bertoni, M.; Bienert, S.; Studer, G.; Tauriello, G.; Gumienny, R.; Heer, F.T.; de Beer, T.A.P.; Rempfer, C.; Bordoli, L.; et al. SWISS-MODEL: Homology modelling of protein structures and complexes. Nucleic Acids Res. 2018, 46, W296–W303. [Google Scholar] [CrossRef]
- Zhou, X.; Zheng, W.; Li, Y.; Pearce, R.; Zhang, C.; Bell, E.W.; Zhang, G.; Zhang, Y. I-TASSER-MTD: A deep-learning-based platform for multi-domain protein structure and function prediction. Nat. Protoc. 2022, 17, 2326–2353. [Google Scholar] [CrossRef]
- Kelley, L.A.; Mezulis, S.; Yates, C.M.; Wass, M.N.; Sternberg, M.J. The Phyre2 web portal for protein modeling, prediction and analysis. Nat. Protoc. 2015, 10, 845–858. [Google Scholar] [CrossRef]
- Daryaei, A.; Jones, E.E.; Ghazalibiglar, H.; Glare, T.R.; Falloon, R.E. Effects of temperature, light and incubation period on production, germination and bioactivity of Trichoderma atroviride. J. Appl. Microbiol. 2016, 120, 999–1009. [Google Scholar] [CrossRef]
- Daryaei, A.; Jones, E.E.; Glare, T.R.; Falloon, R.E. Nutrient amendments affect Trichoderma atroviride conidium production, germination and bioactivity. Biol. Control 2016, 93, 8–14. [Google Scholar] [CrossRef]
- Brunner, K.; Zeilinger, S.; Ciliento, R.; Woo, S.L.; Lorito, M.; Kubicek, C.P.; Mach, R.L. Improvement of the fungal biocontrol agent Trichoderma atroviride to enhance both antagonism and induction of plant systemic disease resistance. Appl. Environ. Microbiol. 2005, 71, 3959–3965. [Google Scholar] [CrossRef]
- Longa, C.M.O.; Pertot, I.; Tosi, S. Ecophysiological requirements and survival of a Trichoderma atroviride isolate with biocontrol potential. J. Basic Microbiol. 2008, 48, 269–277. [Google Scholar] [CrossRef]
- Gil, S.V.; Pastor, S.; March, G.J. Quantitative isolation of biocontrol agents Trichoderma spp., Gliocladium spp. and actinomycetes from soil with culture media. Microbiol. Res. 2009, 164, 196–205. [Google Scholar] [CrossRef]
- Seidl, V.; Song, L.; Lindquist, E.; Gruber, S.; Koptchinskiy, A.; Zeilinger, S.; Schmoll, M.; Martínez, P.; Sun, J.; Grigoriev, I.; et al. Transcriptomic response of the mycoparasitic fungus Trichoderma atroviride to the presence of a fungal prey. BMC Genom. 2009, 10, 567. [Google Scholar] [CrossRef]
- Błaszczyk, L.; Ćwiek-Kupczyńska, H.; Hoppe Gromadzka, K.; Basińska-Barczak, A.; Stępień, Ł.; Kaczmarek, J.; Lenc, L. Containment of Fusarium culmorum and its mycotoxins in various biological systems by antagonistic Trichoderma and Clonostachys strains. J. Fungi 2023, 9, 289. [Google Scholar] [CrossRef]
- González-Pérez, E.; Ortega-Amaro, M.A.; Salazar-Badillo, F.B.; Bautista, E.; Douterlungne, D.; Jiménez-Bremont, J.F. The Arabidopsis-Trichoderma interaction reveals that the fungal growth medium is an important factor in plant growth induction. Sci. Rep. 2018, 8, 16427. [Google Scholar] [CrossRef]
- Dennis, C.; Webster, J. Antagonistic properties of species-groups of Trichoderma: II. Production of volatile antibiotics. Trans. Br. Mycol. Soc. 1971, 57, 41–48. [Google Scholar] [CrossRef]
- Marik, T.; Urbán, P.; Tyagi, C.; Szekeres, A.; Leitgeb, B.; Vágvölgyi, M.; Manczinger, L.; Druzhinina, I.S.; Vágvölgyi, C.; Kredics, L. Diversity profile and dynamics of peptaibols produced by green mould Trichoderma species in interactions with their hosts Agaricus bisporus and Pleurotus ostreatus. Chem. Biodivers. 2017, 14, e1700033. [Google Scholar] [CrossRef]
- Erazo, J.G.; Palacios, S.A.; Pastor, N.; Giordano, F.D.; Rovera, M.; Reynoso, M.M.; Venisse, J.S.; Torres, A.M. Biocontrol mechanisms of Trichoderma harzianum ITEM 3636 against peanut brown root rot caused by Fusarium solani RC 386. Biol. Control 2021, 164, 104774. [Google Scholar] [CrossRef]
- Rahimi-Tamandegani, P.; Marik, T.; Zafari, D.; Balázs, D.; Vágvölgyi, C.; Szekeres, A.; Kredics, L. Changes in peptaibol production of Trichoderma species during in vitro antagonistic interactions with fungal plant pathogens. Biomolecules 2020, 10, 730. [Google Scholar] [CrossRef]
- Mendoza-Mendoza, A.; Pozo, M.J.; Grzegorski, D.; Martínez, P.; García, J.M.; Olmedo-Monfil, V.; Cortés, C.; Kenerley, C.; Herrera-Estrella, A. Enhanced biocontrol activity of Trichoderma through inactivation of a mitogen-activated protein kinase. Proc. Natl. Acad. Sci. USA 2003, 100, 15965–15970. [Google Scholar] [CrossRef]
- Guzmán-Guzmán, P.; Alemán-Duarte, M.I.; Delaye, L.; Herrera-Estrella, A.; Olmedo-Monfil, V. Identification of effector-like proteins in Trichoderma spp. and role of a hydrophobin in the plant-fungus interaction and mycoparasitism. BMC Genet. 2017, 18, 16. [Google Scholar] [CrossRef]
- Gómez-Rodríguez, E.Y.; Uresti-Rivera, E.E.; Patrón-Soberano, O.A.; Islas-Osuna, M.A.; Flores-Martínez, A.; Riego-Ruiz, L.; Rosales-Saavedra, M.T.; Casas-Flores, S. Histone acetyltransferase TGF-1 regulates Trichoderma atroviride secondary metabolism and mycoparasitism. PLoS ONE 2018, 13, e0193872. [Google Scholar] [CrossRef]
- Knudsen, I.M.B.; Hockenhull, J.; Jensen, D.F.; Gerhardson, B.; Hökeberg, M.; Tahvonen, R.; Teperi, E.; Sundheim, L.; Henriksen, B. Selection of biological control agents for controlling soil and seed-borne diseases in the field. Eur. J. Plant Pathol. 1997, 103, 775–784. [Google Scholar] [CrossRef]
- Schubert, M.; Fink, S.; Schwarze, F.W. Evaluation of Trichoderma spp. as a biocontrol agent against wood decay fungi in urban trees. Biol. Control 2008, 45, 111–123. [Google Scholar] [CrossRef]
- Schubert, M.; Fink, S.; Schwarze, F.W. In vitro screening of an antagonistic Trichoderma strain against wood decay fungi. Arboric. J. 2008, 31, 227–248. [Google Scholar] [CrossRef]
- Moreno-Mateos, M.A.; Delgado-Jarana, J.; Codon, A.C.; Benítez, T. pH and Pac1 control development and antifungal activity in Trichoderma harzianum. Fungal Genet. Biol. 2007, 44, 1355–1367. [Google Scholar] [CrossRef]
- Gezgin, Y.; Maral Gül, D.; Sözer Şenşatar, S.; Kara, C.U.; Sargın, S.; Sukan, F.V.; Eltem, R. Evaluation of Trichoderma atroviride and Trichoderma citrinoviride growth profiles and their potentials as biocontrol agent and biofertilizer. Turk. J. Chem. 2020, 45, 163–175. [Google Scholar] [CrossRef]
- Friedl, M.A.; Kubicek, C.P.; Druzhinina, I.S. Carbon source dependence and photostimulation of conidiation in Hypocrea atroviridis. Appl. Environ. Microbiol. 2008, 74, 245–250. [Google Scholar] [CrossRef]
- Friedl, M.A.; Schmoll, M.; Kubicek, C.P.; Druzhinina, I.S. Photostimulation of Hypocrea atroviridis growth occurs due to a cross-talk of carbon metabolism, blue light receptors and response to oxidative stress. Microbiology 2008, 154, 1229–1241. [Google Scholar] [CrossRef][Green Version]
- Reithner, B.; Schuhmacher, R.; Stoppacher, N.; Pucher, M.; Brunner, K.; Zeilinger, S. Signaling via the Trichoderma atroviride mitogen-activated protein kinase Tmk1 differentially affects mycoparasitism and plant protection. Fungal Genet. Biol. 2007, 44, 1123–1133. [Google Scholar] [CrossRef]
- Beever, R.E.; Bollard, E.G. The nature of the stimulation of fungal growth by potato extract. Microbiology 1970, 60, 273–279. [Google Scholar] [CrossRef]
- Abiala, M.A.; Ogunjobi, A.A.; Odebode, A.C.; Ayodele, M.A. Evaluation of plant extracts as an antagonist to mycelial growth of Mycosphaerella fijiensis morelet. Arch. Phytopathol. Plant Protect. 2011, 44, 1711–1718. [Google Scholar] [CrossRef]
- Adelusi, O.A.; Gbashi, S.; Adebiyi, J.A.; Makhuvele, R.; Adebo, O.A.; Aasa, A.O.; Targuma, S.; Kah, G.; Njobeh, P.B. Variability in metabolites produced by Talaromyces pinophilus SPJ22 cultured on different substrates. Fungal Biol. Biotechnol. 2022, 9, 15. [Google Scholar] [CrossRef]
- Demyttenaere, J.C.; Moriña, R.M.; De Kimpe, N.; Sandra, P. Use of headspace solid-phase microextraction and headspace sorptive extraction for the detection of the volatile metabolites produced by toxigenic Fusarium species. J. Chromatogr. A 2004, 1027, 147–154. [Google Scholar] [CrossRef]
- Ulrich, S.; Schäfer, C. Toxin production by Stachybotrys chartarum genotype S on different culture media. J. Fungi 2020, 6, 159. [Google Scholar] [CrossRef]
- Wolna-Maruwka, A.; Dach, J.; Rafaela, C.; Czekała, W.; Niewiadomska, A.; Janczak, D.; Budka, A. An effective method of utilizing vegetable waste in the form of carriers for Trichoderma strains with phytosanitary properties. Sci. Total Environ. 2019, 671, 795–804. [Google Scholar] [CrossRef]
- Steyaert, J.M.; Weld, R.J.; Mendoza-Mendoza, A.; Stewart, A. Reproduction without sex: Conidiation in the filamentous fungus Trichoderma. Microbiology 2010, 156, 2887–2900. [Google Scholar] [CrossRef]
- Steyaert, J.M.; Weld, R.J.; Stewart, A. Isolate-specific conidiation in Trichoderma in response to different nitrogen sources. Fungal Biol. 2010, 114, 179–188. [Google Scholar] [CrossRef]
- Mukherjee, P.K.; Mendoza-Mendoza, A.; Zeilinger, S.; Horwitz, B.A. Mycoparasitism as a mechanism of Trichoderma-mediated suppression of plant diseases. Fungal Biol. Rev. 2022, 39, 15–33. [Google Scholar] [CrossRef]
- Li, M.F.; Li, G.H.; Zhang, K.Q. Non-volatile metabolites from Trichoderma spp. Metabolites 2019, 9, 58. [Google Scholar] [CrossRef]
- Bae, S.J.; Mohanta, T.K.; Chung, J.Y.; Ryu, M.; Park, G.; Shim, S.; Hong, S.B.; Seo, H.; Bae, D.W.; Bae, I.; et al. Trichoderma metabolites as biological control agents against Phytophthora pathogens. Biol. Control 2016, 92, 128–138. [Google Scholar] [CrossRef]
- Pagáč, T.; Kubová, Z.; Víglaš, J.; Kavalová, Z.; Olejníková, P. Study on secondary metabolites of F742 and their role in antibiosis. Acta Chim. Slov. 2023, 16, 12–21. [Google Scholar] [CrossRef]
- Mukherjee, M.; Mukherjee, P.K.; Horwitz, B.A.; Zachow, C.; Berg, G.; Zeilinger, S. Trichoderma–plant–pathogen interactions: Advances in genetics of biological control. Indian. J. Microbiol. 2012, 52, 522–529. [Google Scholar] [CrossRef]
- Moreno-Ruiz, D.; Lichius, A.; Turrà, D.; Di Pietro, A.; Zeilinger, S. Chemotropism assays for plant symbiosis and mycoparasitism related compound screening in Trichoderma atroviride. Front. Microbiol. 2020, 11, 601251. [Google Scholar] [CrossRef]
- Druzhinina, I.S.; Seidl-Seiboth, V.; Herrera-Estrella, A.; Horwitz, B.A.; Kenerley, C.M.; Monte, E.; Mukherjee, P.K.; Zeilinger, S.; Grigoriev, I.V.; Kubicek, C.P. Trichoderma: The genomics of opportunistic success. Nat. Rev. Microbiol. 2011, 9, 749–759. [Google Scholar] [CrossRef]
- Ferreira, F.V.; Herrmann-Andrade, A.M.; Calabrese, C.D.; Bello, F.; Vázquez, D.; Musumeci, M.A. Effectiveness of Trichoderma strains isolated from the rhizosphere of citrus tree to control Alternaria alternata, Colletotrichum gloeosporioides and Penicillium digitatum A21 resistant to pyrimethanil in post-harvest oranges (Citrus sinensis L. (Osbeck)). J. Appl. Microbiol. 2020, 129, 712–727. [Google Scholar] [CrossRef]
- Sánchez, A.D.; Ousset, M.J.; Sosa, M.C. Biological control of Phytophthora collar rot of pear using regional Trichoderma strains with multiple mechanisms. Biol. Control 2019, 135, 124–134. [Google Scholar] [CrossRef]
- Liu, K.; Zhang, Y.Z.; Du, H.Y.; Wang, Z.Y.; Gu, P.W.; Liu, Z.H.; Yu, Z.Y. Beneficial and biocontrol effects of Trichoderma atroviride, a dominant species in white birch rhizosphere soil. Front. Microbiol. 2023, 14, 1265435. [Google Scholar] [CrossRef]
- Kim, S.H.; Lee, Y.; Balaraju, K.; Jeon, Y. Evaluation of Trichoderma atroviride and Trichoderma longibrachiatum as biocontrol agents in controlling red pepper anthracnose in Korea. Front. Plant Sci. 2023, 14, 1201875. [Google Scholar] [CrossRef]
- Vinale, F.; Sivasithamparam, K.; Ghisalberti, E.L.; Marra, R.; Woo, S.L.; Lorito, M. Trichoderma–plant–pathogen interactions. Soil Biol. Biochem. 2008, 40, 1–10. [Google Scholar] [CrossRef]
- Card, S.D.; Walter, M.; Jaspers, M.V.; Sztejnberg, A.; Stewart, A. Targeted selection of antagonistic microorganisms for control of Botrytis cinerea of strawberry in New Zealand. Australasian Plant Pathol. 2009, 38, 183–192. [Google Scholar] [CrossRef]
- Dean, R.; Van Kan, J.A.; Pretorius, Z.A.; Hammond-Kosack, K.E.; Di Pietro, A.; Spanu, P.D.; Rudd, J.J.; Dickman, M.; Kahmann, R.; Ellis, J.; et al. The Top 10 fungal pathogens in molecular plant pathology. Mol. Plant Pathol. 2012, 13, 414–430. [Google Scholar] [CrossRef]
- Roca-Couso, R.; Flores-Félix, J.D.; Rivas, R. Mechanisms of action of microbial biocontrol agents against Botrytis cinerea. J. Fungi 2021, 7, 1045. [Google Scholar] [CrossRef]
- Li, T.T.; Zhang, J.D.; Tang, J.Q.; Liu, Z.C.; Li, Y.Q.; Chen, J.; Zou, L.W. Combined use of Trichoderma atroviride CCTCCSBW0199 and brassinolide to control Botrytis cinerea infection in tomato. Plant Dis. 2020, 104, 1298–1304. [Google Scholar] [CrossRef]
- Coninck, E.; Scauflaire, J.; Gollier, M.; Liénard, C.; Foucart, G.; Manssens, G.; Munaut, F.; Legrève, A. Trichoderma atroviride as a promising biocontrol agent in seed coating for reducing Fusarium damping-off on maize. J. Appl. Microbiol. 2020, 120, 637–651. [Google Scholar] [CrossRef]
- Gomes, E.N.; Elsherbiny, E.A.; Aleem, B.; Bennett, J.W. Beyond classical biocontrol: New perspectives on Trichoderma. In Fungal Biotechnology and Bioengineering; Springer: Cham, Switzerland, 2020; pp. 437–455. [Google Scholar] [CrossRef]
- Elsherbiny, E.A.; Amin, B.H.; Aleem, B.; Kingsley, K.L.; Bennett, J.W. Trichoderma volatile organic compounds as a biofumigation tool against late blight pathogen Phytophthora infestans in postharvest potato tubers. J. Agric. Food Chem. 2020, 68, 8163–8171. [Google Scholar] [CrossRef]
- Bello, F.; Montironi, I.D.; Medina, M.B.; Munitz, M.S.; Ferreira, F.V.; Williman, C.; Vázquez, D.; Cariddi, L.N.; Musumeci, M.A. Mycofumigation of postharvest blueberries with volatile compounds from Trichoderma atroviride IC-11 is a promising tool to control rots caused by Botrytis cinerea. Food Microbiol. 2022, 106, 104040. [Google Scholar] [CrossRef]
- van Zijll de Jong, E.; Kandula, J.; Rostás, M.; Kandula, D.; Hampton, J.; Mendoza-Mendoza, A. Fungistatic activity mediated by volatile organic compounds is isolate-dependent in Trichoderma sp. “atroviride B”. J. Fungi 2023, 9, 238. [Google Scholar] [CrossRef]
- Martínez-Medina, A.; Van Wees, S.C.; Pieterse, C.M. Airborne signals from Trichoderma fungi stimulate iron uptake responses in roots resulting in priming of jasmonic acid-dependent defences in shoots of Arabidopsis thaliana and Solanum lycopersicum. Plant Cell Environ. 2017, 40, 2691–2705. [Google Scholar] [CrossRef]
- You, J.; Li, G.; Li, C.; Zhu, L.; Yang, H.; Song, R.; Gu, W. Biological control and plant growth promotion by volatile organic compounds of Trichoderma koningiopsis T-51. J. Fungi 2022, 8, 131. [Google Scholar] [CrossRef]
- Poveda, J.; Abril-Urias, P.; Escobar, C. Biological control of plant-parasitic nematodes by filamentous fungi inducers of resistance: Trichoderma, mycorrhizal and endophytic fungi. Front. Microbiol. 2020, 11, 530260. [Google Scholar] [CrossRef]
- El_Komy, M.H.; Saleh, A.A.; Eranthodi, A.; Molan, Y.Y. Characterization of novel Trichoderma asperellum isolates to select effective biocontrol agents against tomato Fusarium wilt. Plant Pathol. J. 2015, 31, 50–60. [Google Scholar] [CrossRef]
- Moka, S.; Singh, N.; Buttar, D.S. Identification of potential native chitinase-producing Trichoderma spp. and its efficacy against damping-off in onion. Eur. J. Plant Pathol. 2021, 161, 289–300. [Google Scholar] [CrossRef]
- De la Cruz, J.; Rey, M.; Lora, J.M.; Hidalgo-Gallego, A.; Domínguez, F.; Pintor-Toro, J.A.; Llobell, A.; Benítez, T. Carbon source control on β-glucanases, chitobiase and chitinase from Trichoderma harzianum. Arch. Microbiol. 1993, 159, 316–322. [Google Scholar] [CrossRef]
- Mach, R.L.; Peterbauer, C.K.; Payer, K.; Jaksits, S.; Woo, S.L.; Zeilinger, S.; Kullnig, C.M.; Lorito, M.; Kubicek, C.P. Expression of two major chitinase genes of Trichoderma atroviride (T. harzianum P1) is triggered by different regulatory signals. Appl. Environ. Microbiol. 1999, 65, 1858–1863. [Google Scholar] [CrossRef]
- Seidl, V.; Huemer, B.; Seiboth, B.; Kubicek, C.P. A complete survey of Trichoderma chitinases reveals three distinct subgroups of family 18 chitinases. FASEB J. 2005, 272, 5923–5939. [Google Scholar] [CrossRef]
- Seidl, V. Chitinases of filamentous fungi: A large group of diverse proteins with multiple physiological functions. Fungal Biol. Rev. 2008, 22, 36–42. [Google Scholar] [CrossRef]
- Gruber, S.; Seidl-Seiboth, V. Self versus non-self: Fungal cell wall degradation in Trichoderma. Microbiology 2012, 158, 26–34. [Google Scholar] [CrossRef]
- Carsolio, C.; Gutiérrez, A.; Jiménez, B.; Van Montagu, M.; Herrera-Estrella, A. Characterization of ech-42, a Trichoderma harzianum endochitinase gene expressed during mycoparasitism. Proc. Natl. Acad. Sci. USA 1994, 91, 10903–10907. [Google Scholar] [CrossRef]
- Zeilinger, S.; Galhaup, C.; Payer, K.; Woo, S.L.; Mach, R.L.; Fekete, C.; Matteo, L.; Kubicek, C.P. Chitinase Gene expression during mycoparasitic interaction of Trichoderma harzianum with its host. Fungal Genet. Biol. 1999, 26, 131–140. [Google Scholar] [CrossRef]
- Kullnig, C.M.; Mach, R.L.; Lorito, M.; Kubicek, C.P. Enzyme diffusion from Trichoderma atroviride (=Trichoderma harzianum) to Rhizoctonia solani is a prerequisite for triggering Trichoderma ech42 gene expression before mycoparasitic contact. Appl. Environ. Microbiol. 2000, 66, 2232–2234. [Google Scholar] [CrossRef]
- Troian, R.F.; Steindorff, A.S.; Ramada, M.H.S.; Arruda, W.; Ulhoa, C.J. Mycoparasitism studies of Trichoderma harzianum against Sclerotinia sclerotiorum: Evaluation of antagonism and expression of cell wall-degrading enzymes genes. Biotechnol. Lett. 2014, 36, 2095–2101. [Google Scholar] [CrossRef]
- de las Mercedes-Dana, M.; Limón, M.C.; Mejías, R.; Mach, R.L.; Benítez, T.; Pintor-Toro, J.A.; Kubicek, C.P. Regulation of chitinase 33 (chit33) gene expression in Trichoderma harzianum. Curr Genet. 2001, 38, 335–342. [Google Scholar] [CrossRef]
- Szabó, M.; Csepregi, K.; Gálber, M.; Virányi, F.; Fekete, C. Control plant-parasitic nematodes with Trichoderma species and nematode-trapping fungi: The role of chi18-5 and chi18-12 genes in nematode egg-parasitism. Biol. Control 2012, 63, 121–128. [Google Scholar] [CrossRef]
- Ubhayasekera, W.; Karlsson, M. Bacterial and fungal chitinase chiJ orthologs evolve under different selective constraints following horizontal gene transfer. BMC Res. Notes 2012, 5, 581. [Google Scholar] [CrossRef]
- Ihrmark, K.; Asmail, N.; Ubhayasekera, W.; Melin, P.; Stenlid, J.; Karlsson, M. Comparative molecular evolution of Trichoderma chitinases in response to mycoparasitic interactions. Evol. Bioinf. 2010, 6, EBO-S4198. [Google Scholar] [CrossRef]
- Viterbo, A.; Montero, M.; Ramot, O.; Friesem, D.; Monte, E.; Llobell, A.; Chet, I. Expression regulation of the endochitinase chit36 from Trichoderma asperellum (T. harzianum T-203). Curr. Genet. 2002, 42, 114–122. [Google Scholar] [CrossRef]
- Viterbo, A.; Haran, S.; Friesem, D.; Ramot, O.; Chet, I. Antifungal activity of a novel endochitinase gene (chit36) from Trichoderma harzianum Rifai TM. FEMS Microbiol. Lett. 2001, 200, 169–174. [Google Scholar] [CrossRef]
- Schmoll, M.; Dattenböck, C.; Carreras-Villasenor, N.; Mendoza-Mendoza, A.; Tisch, D.; Aleman, M.I.; Baker, S.E.; Brown, C.; Cervantes-Badillo, M.G.; Cetz-Chel, J.; et al. The genomes of three uneven siblings: Footprints of the lifestyles of three Trichoderma species. Microbiol. Mol. Biol. Rev. 2016, 80, 205–327. [Google Scholar] [CrossRef]
- Wohlbach, D.J.; Thompson, D.A.; Gasch, A.P.; Regev, A. From elements to modules: Regulatory evolution in Ascomycota fungi. Curr. Opin. Genet. Dev. 2009, 19, 571–578. [Google Scholar] [CrossRef]
- Thompson, D.A.; Regev, A. Fungal regulatory evolution: Cis and trans in the balance. FEBS Lett. 2009, 583, 3959–3965. [Google Scholar] [CrossRef]
- Cantu, D.; Greve, L.C.; Labavitch, J.M.; Powell, A.L. Characterization of the cell wall of the ubiquitous plant pathogen Botrytis cinerea. Mycol. Res. 2009, 113, 1396–1403. [Google Scholar] [CrossRef]
- Schoffelmeer, E.A.M.; Klis, F.M.; Sietsma, J.H.; Cornelissen, B.J. The cell wall of Fusarium oxysporum. Fungal Genet. Biol. 1999, 27, 275–282. [Google Scholar] [CrossRef]

| Strain ID | Species | Crop/Plant of Isolation | Locality of Origin 1 |
|---|---|---|---|
| BC-MICH | Botrytis cinerea | Strawberry (Fragaria × ananassa) | Uruapan |
| FS-MICH | Fusarium sp. | Blackberry (Rubus ulmifolius) | Los Reyes |
| MICMM21 | Fusarium mexicanum | Mango (Mangifera indica) | Buenavista Tomatlán |
| CCJT-1 | Colletotrichum coccodes | Tomato (Solanum lycopersicum) | Morelia |
| CG1-MICH | Colletotrichum gloeosporioides | Formio (Phormium tenax) | Morelia |
| CG2-MICH | Colletotrichum gloeosporioides | Avocado (Persea americana) | Uruapan |
| PC2-MICH | Phytophthora cinnamomi | Avocado (Persea americana) | Uruapan |
| Locus(gen)/Oligonucleotide | Sequence (5’→3’) 1 |
|---|---|
| chit33 | |
| 49766RT-Fwd | GCTTCGCCATCGCAGCTGGC |
| 49766RT-Rev | CAGGCCCGACGGGAAGCG |
| chit36 | |
| 83999RT-Fwd | CCAAAACGGCCGACTGTGGTGG |
| 83999RT-Rev | GCCCCCGCCAGCTCCATTTTG |
| ech42 | |
| 131598RT-Fwd | CCATTGCTGCCCCCGCTGG |
| 131598RT-Rev | GGTCTGGCCAATGCCACCGG |
| TRIATDRAFT_217415 | |
| 217415RT-Fwd | CAGCGGCTTCGGCACCATGG |
| 217415RT-Rev | CAGGCCAGGGCGCAGAATCTC |
| Phytopathogen (Strain) | Antagonism Level in Each Culture Medium | |
|---|---|---|
| VMM | PDA | |
| B. cinerea (BC-MICH) | 1 a | 1 a |
| Fusarium sp. (FS-MICH) | 1 a | 1 a |
| F. mexicanum (MICMM21) | 1 a | 2 b |
| C. coccodes (CCJT-1) | 1 a | 2 b |
| C. gloeosporioides (CG1-MICH) | 1 a | 2 b |
| C. gloeosporioides (CG2-MICH) | 2 b | 2 c |
| P. cinnamomi (PC2-MICH) | 1 a | 1 a |
| Phytopathogen (Strain) | Inhibition Class in Each Culture Medium | |
|---|---|---|
| VMM | PDA | |
| B. cinerea (BC-MICH) | 3 (31.54) b,c | 3 (16.26) a,b |
| Fusarium sp. (FS-MICH) | 3 (30.55) b,c | 3 (0) a |
| F. mexicanum (MICMM21) | 3 (25) b,c | 3 (0.41) a |
| C. coccodes (CCJT-1) | 1 (100) e | 1 (91.67) e |
| C. gloeosporioides (CG1-MICH) | 1 (100) e | 1 (93.02) e |
| C. gloeosporioides (CG2-MICH) | 1 (92.85) e | 2 (38.09) c |
| P. cinnamomi (PC2-MICH) | 1 (70.23) d | 3 (8.73) a |
| Phytopathogen (Strain) | Inhibition Class in Each Culture Medium | |
|---|---|---|
| VMM | PDA | |
| B. cinerea (BC-MICH) | 2 (50.25) c, d, e | 2 (48.8) a, b, c, d, e |
| Fusarium sp. (FS-MICH) | 2 (51.19) a, b, c, d, e | 2 (46.42) a, b, c, d, e |
| F. mexicanum (MICMM21) | 2 (59.69) b, c, d, e | 3 (27.24) a, b |
| C. coccodes (CCJT-1) | 2 (59.12) c, d, e | 2 (60.83) c, d, e |
| C. gloeosporioides (CG1-MICH) | 2 (39.39) c, d, e | 2 (46.89) a, b, c, d, e |
| C. gloeosporioides (CG2-MICH) | 2 (63.39) c, d, e | 1 (68.65) c, d, e |
| P. cinnamomi (PC2-MICH) | 1 (70.19) c, d, e | 2 (50.39) a, b, c, d, e |
Disclaimer/Publisher’s Note: The statements, opinions and data contained in all publications are solely those of the individual author(s) and contributor(s) and not of MDPI and/or the editor(s). MDPI and/or the editor(s) disclaim responsibility for any injury to people or property resulting from any ideas, methods, instructions or products referred to in the content. |
© 2024 by the authors. Licensee MDPI, Basel, Switzerland. This article is an open access article distributed under the terms and conditions of the Creative Commons Attribution (CC BY) license (https://creativecommons.org/licenses/by/4.0/).
Share and Cite
González-Martínez, K.I.; Vázquez-Garcidueñas, M.S.; Herrera-Estrella, A.; Fernández-Pavía, S.P.; Salgado-Garciglia, R.; Larsen, J.; Ochoa-Ascencio, S.; Rodríguez-Alvarado, G.; Vázquez-Marrufo, G. Polyphasic Characterization of the Biocontrol Potential of a Novel Strain of Trichoderma atroviride Isolated from Central Mexico. J. Fungi 2024, 10, 758. https://doi.org/10.3390/jof10110758
González-Martínez KI, Vázquez-Garcidueñas MS, Herrera-Estrella A, Fernández-Pavía SP, Salgado-Garciglia R, Larsen J, Ochoa-Ascencio S, Rodríguez-Alvarado G, Vázquez-Marrufo G. Polyphasic Characterization of the Biocontrol Potential of a Novel Strain of Trichoderma atroviride Isolated from Central Mexico. Journal of Fungi. 2024; 10(11):758. https://doi.org/10.3390/jof10110758
Chicago/Turabian StyleGonzález-Martínez, Karla Ivonne, Ma. Soledad Vázquez-Garcidueñas, Alfredo Herrera-Estrella, Sylvia P. Fernández-Pavía, Rafael Salgado-Garciglia, John Larsen, Salvador Ochoa-Ascencio, Gerardo Rodríguez-Alvarado, and Gerardo Vázquez-Marrufo. 2024. "Polyphasic Characterization of the Biocontrol Potential of a Novel Strain of Trichoderma atroviride Isolated from Central Mexico" Journal of Fungi 10, no. 11: 758. https://doi.org/10.3390/jof10110758
APA StyleGonzález-Martínez, K. I., Vázquez-Garcidueñas, M. S., Herrera-Estrella, A., Fernández-Pavía, S. P., Salgado-Garciglia, R., Larsen, J., Ochoa-Ascencio, S., Rodríguez-Alvarado, G., & Vázquez-Marrufo, G. (2024). Polyphasic Characterization of the Biocontrol Potential of a Novel Strain of Trichoderma atroviride Isolated from Central Mexico. Journal of Fungi, 10(11), 758. https://doi.org/10.3390/jof10110758

